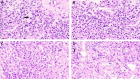

Unusual case report of malignant pheochromocytoma presenting with STEMI
- PMID: 37408528
- PMCID: PMC10319448
- DOI: 10.1093/ehjcr/ytad249
Unusual case report of malignant pheochromocytoma presenting with STEMI
Abstract
Background: Pheochromocytomas (PHEOs) are a group of tumours that leads to multiple symptoms and can induce hypercoagulability and promote thrombosis. Pheochromocytomas may also present without elevated serum and urinary markers. We aimed to provide tips and tricks for the diagnostic and therapeutic management of an unusual case of PHEOs.
Case summary: Thirty-four-year-old woman with the unremarkable medical history presented with epigastric pain and dyspnoea. Electrocardiogram showed ST-segment elevation in the inferior limb leads. She underwent an emergency coronary angiogram, which showed a high thrombus burden in the distal right coronary artery. A subsequent echocardiogram demonstrated a 31 × 33 mm right atrial mass adhering to the inferior vena cava and abdominal computed tomography (CT) scan revealed a 113 × 85 mm necrotic mass in the left adrenal bed, with tumour thrombus extending proximally to the confluence of hepatic veins immediately inferior to the right atrium and distally to iliac vein bifurcation. Blood parameters, thrombophilia panel, vanillylmandelic acid, 5 hydroxy indole acetic acid, and homovanillic acid levels were normal. Tissue sampling confirmed the diagnosis of PHEOs. The surgical procedure was not planned due to the presence of metastatic foci on imaging, including positron emission tomography (PET)-CT. Anticoagulation with rivaroxaban and treatment with 177Lu-DOTATATE-based peptide receptor radionuclide therapy (PRRT) was initiated.
Discussion: The coexistence of arterial and venous thrombosis is extremely rare in patients with PHEOs. Multidisciplinary approaches are required for the care of such patients. Catecholamines likely contributed to the development of thrombosis in our patient. Early recognition of PHEOs is the key point to ameliorate clinical outcomes.
Keywords: Acute coronary syndrome; Case reports; Pheochromocytoma; Pulmonary embolisms.
© The Author(s) 2023. Published by Oxford University Press on behalf of the European Society of Cardiology.
Conflict of interest statement
Conflict of interest: None declared.
Figures

References
-
- Pacak K, Linehan WM, Eisenhofer G, Walther MM, Goldstein DS. Recent advances in genetics, diagnosis, localization, and treatment of PHEOs. Ann Intern Med 2001;134:315–329. - PubMed
-
- Stein PP, Black HR. A simplified diagnostic approach to PHEOs. A review of the literature and report of one institution’s experience. Medicine (Baltimore) 1991;70:46–66. - PubMed
-
- Lenders JW, Eisenhofer G, Mannelli M, Pacak K. Phaeochromocytoma. Lancet 2005;366:665–675. - PubMed
-
- Reisch N, Peczkowska M, Januszewicz A, Neumann HP. Pheochromocytoma: presentation, diagnosis and treatment. J Hypertens 2006;24:2331–2339. - PubMed
-
- van Zaane B, Stuijver DJ, Squizzato A, Gerdes VE. Arterial and venous thrombosis in endocrine diseases. Semin Thromb Hemost 2013;39:489–495. - PubMed
Publication types
LinkOut - more resources
Full Text Sources
Miscellaneous
